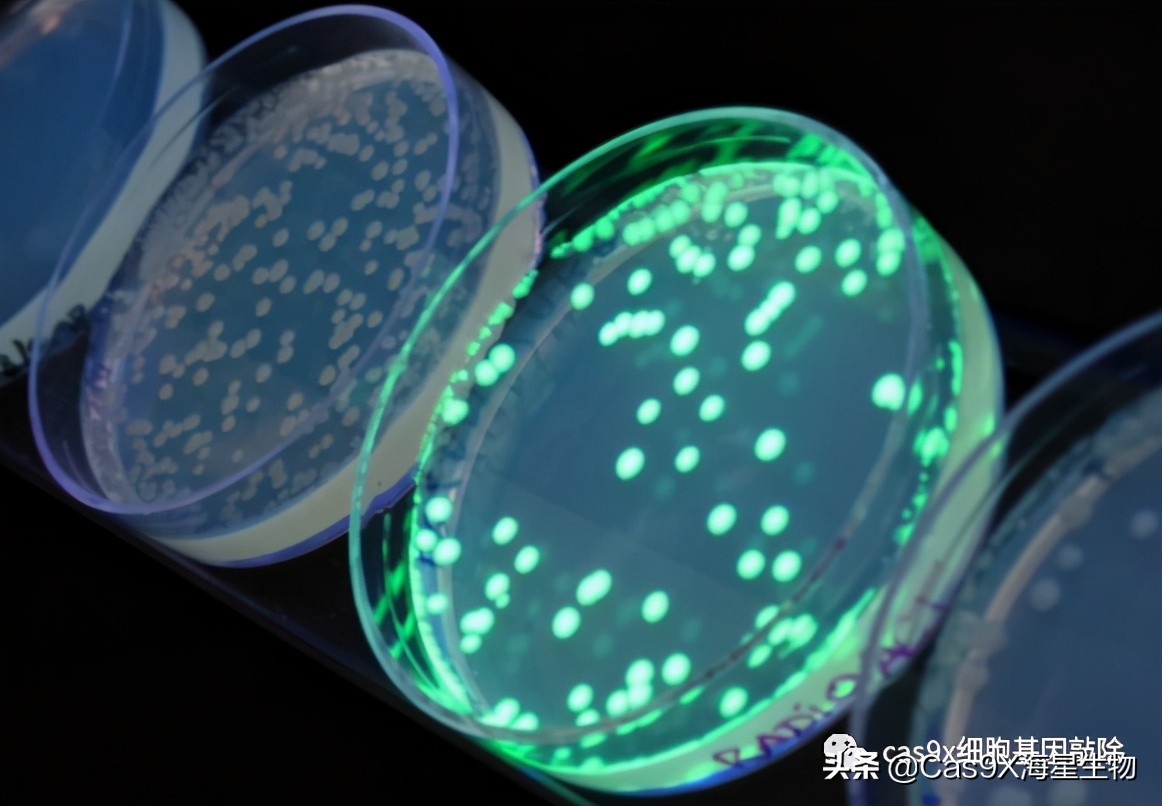
绿色荧光蛋白的发现史,科学家眼里的肽

荧光蛋白想必大家都不陌生,早在1962年,下村修从维多利亚多管水母中分离到一种能在紫外线激发下发出绿色荧光的蛋白,即绿色荧光蛋白 (GFP) 。此后马丁·查尔菲首次将GFP应用于生物学研究,他通过分子生物学技术将GFP的cDNA在线虫等模式生物中表达,使人们意识到GFP作为报告基因的巨大潜力。钱永健团队解析了GFP的发光机制,并通过突变对GFP改造,得到了一些荧光亮度更高、吸收峰单一、构象折叠效率高的突变体,如GFP-S65T。为了表彰他们在绿色荧光蛋白研究中做出的巨大贡献,2008年诺贝尔化学奖授予了下村修、马丁·查尔菲和钱永健三位科学家。

在绿色荧光蛋白首次面世后,科学家们又相继发现研究出其他荧光蛋白,1999年,Matz等从珊瑚虫中分离出了能在紫外照射下发出红色荧光的蛋白质—红色荧光蛋白 (RFP) 。相比于GFP,它有更高的荧光强度,成像背景低,并能激发和发射更长的波长。很多时候,研究者可同时使用GFP和Ds Red对不同蛋白质进行双标记可完成GFP无法独自解决的问题。
随后科研人员基于光谱特性作了进一步的改造,得到了不同颜色的突变体。例如,突变GFP获得了蓝色荧光蛋白(BFP) 、青色荧光蛋白 (CFP) 、绿色荧光蛋白 (GFP) 和黄色荧光蛋白 (YFP) 四组不同颜色的荧光蛋白,其光谱范围覆盖蓝色至黄色。RFP突变衍生出了橙色、红色和近红外光谱的荧光蛋白。以上变种的光谱几乎覆盖了可见光范围,也提高了荧光蛋白标记选择的灵活性,也缔造了生物科学界的“彩虹”。

荧光蛋白不仅是科研人员眼中五彩斑斓的色彩,更是强有力的研究工具,荧光标记和示踪是荧光蛋白最基本的功能,也是目前细胞生物学研究的重要手段。例如,研究一种蛋白质在细胞中的分布时,可将目的蛋白基因和荧光蛋白基因融合到同一质粒中,构建融合基因表达载体,并转染至细胞内,表达的融合蛋白能行使目的蛋白的生物学功能,又有荧光蛋白的发光特点。随后借助激光共聚焦显微镜分析目的蛋白的亚细胞定位以及进行启动子分析、基因表达调控等的研究。
除了荧光标记和蛋白示踪功能之外,蛋白质互作研究也是荧光蛋白的重要作用。目前,基于荧光蛋白的荧光共振能量转移 (FRET) 技术和荧光互补 (FC) 技术已成为研究蛋白互作的有效手段。以FRET技术为例,FRET现象涉及两种荧光蛋白,分别作供体和受体, 要求供体的发射谱与受体的吸收谱重叠,当两者距离很近时 (1~10 nm) ,光子能量将从供体转移至受体,使受体发出荧光,表明蛋白间存在相互作用。

荧光蛋白具有那么多的用途,那么我们如何在科研中选择合适的荧光蛋白进行实验呢?我们需要考虑以下几个方面:
1. 单体性质
将荧光蛋白与目标蛋白进行融合表达,直接地追踪目标蛋白或是定位目标蛋白,这就要求荧光蛋白是单体,不能影响目标蛋白的功能和定位。因此,我们将荧光蛋白的单体性质放在第一位。目前体外检测荧光蛋白单体性质的方法有分子筛、沉降平衡,可以通过荧光蛋白分子筛的峰图是否狭窄,单一粗略的判断其是否为单体,沉降平衡能够更加准确的确认其聚合性质。我们使用荧光蛋白几乎都是在细胞内或组织内,因此我们更加关心在生理条件下,荧光蛋白的聚合性质。在绿色荧光蛋白中单体性质比较好的是 mEmerald,该蛋白很少形成大的点状结构,并且目前还没有称该蛋白会影响定位的报道。相比之下红色荧光蛋白中没有一个单体性质特别好,相比较来说,mApple 的单体性质最好,但是在使用该蛋白的过程中,发现 mAppple 会影响某些蛋白的定位。
2. 成熟时间
荧光蛋白在发光之前需要经历转录、翻译、折叠等步骤,其中折叠过程占据了大部分时间,我们将此过程称之为成熟时间。在标记短寿命的目标蛋白时,如果荧光蛋白的成熟时间太长,可能会出现在目标蛋白开始降解时,荧光蛋白还没有发光,导致无法追踪及定位目标蛋白。因此在选择荧光蛋白时,需要考虑其成熟时间。mEmerald、Dendra2 的成熟时间比较快,在用 Lipo2000 转染试剂盒转染 U2OS 细胞时,转染后四个小时就能够用荧光显微镜观察到了荧光信号,EGFP 没有信号。但是在用 P450 方法检测时,Dendra2 会形成很大的聚集,表明该荧光蛋白的单体性质不好,有可能影响目标蛋白的定位和功能,在使用该蛋白的过程中应该注意这个特性。
3. PK值
每个荧光蛋白都有其最合适的 pH 值,即在一定的 pH 值下,荧光强度最高。有的荧光蛋白适合在酸性环境下使用,相反有的适合在碱性环境下使用,因此在选择荧光蛋白时需要考虑荧光蛋白的 PK 值。在细胞内,大多数细胞器内及细胞质的 pH 值都在 7.0 左右,然而溶酶体内的 pH 值就比较低,因此常规的荧光蛋白并不适合用于标记溶酶体内的蛋白。mCherry 的 PK 值比较低,适合在酸性的环境下使用,可以用于标记溶酶体内的蛋白,但是该荧光蛋白有一定的二聚性质,可能会影响目标蛋白的定位。

4. N端或C端
荧光蛋白与目的蛋白融合表达可能会影响目的蛋白的折叠,这取决于目的蛋白折叠过程中,荧光蛋白所在的那一端有没有参与蛋白质的折叠。例如,如果目的蛋白的 C 端会被折叠入目的蛋白的内侧,那么我们把荧光蛋白标记在目的蛋白的 C 端,将获得不到荧光信号;有些目的蛋白在后翻译的过程会切掉一段,如果荧光蛋白处于被切的一端,那么就不能获得准确的目的蛋白的定位信息。如果标记的目的蛋白是一个新的蛋白,建议分别进行 N 端和 C 端融合表达,以此来确定哪一个是最好的选择。
当然选择荧光蛋白的注意事项不止以上提及的方面,需要结合实际情况进行选择,希望能给热爱科研的你提供帮助。
- 作者:海星生物
- 公众号:Cas9X细胞基因编辑
- 以上内容由海星生物(http://www.cas9x.com)提供
- 服务内容:CRISPR/Cas9细胞基因编辑 载体构建/病毒包装 PDO/动物模型CDX 稳转细胞株 干细胞/原代细胞 培养试剂盒
